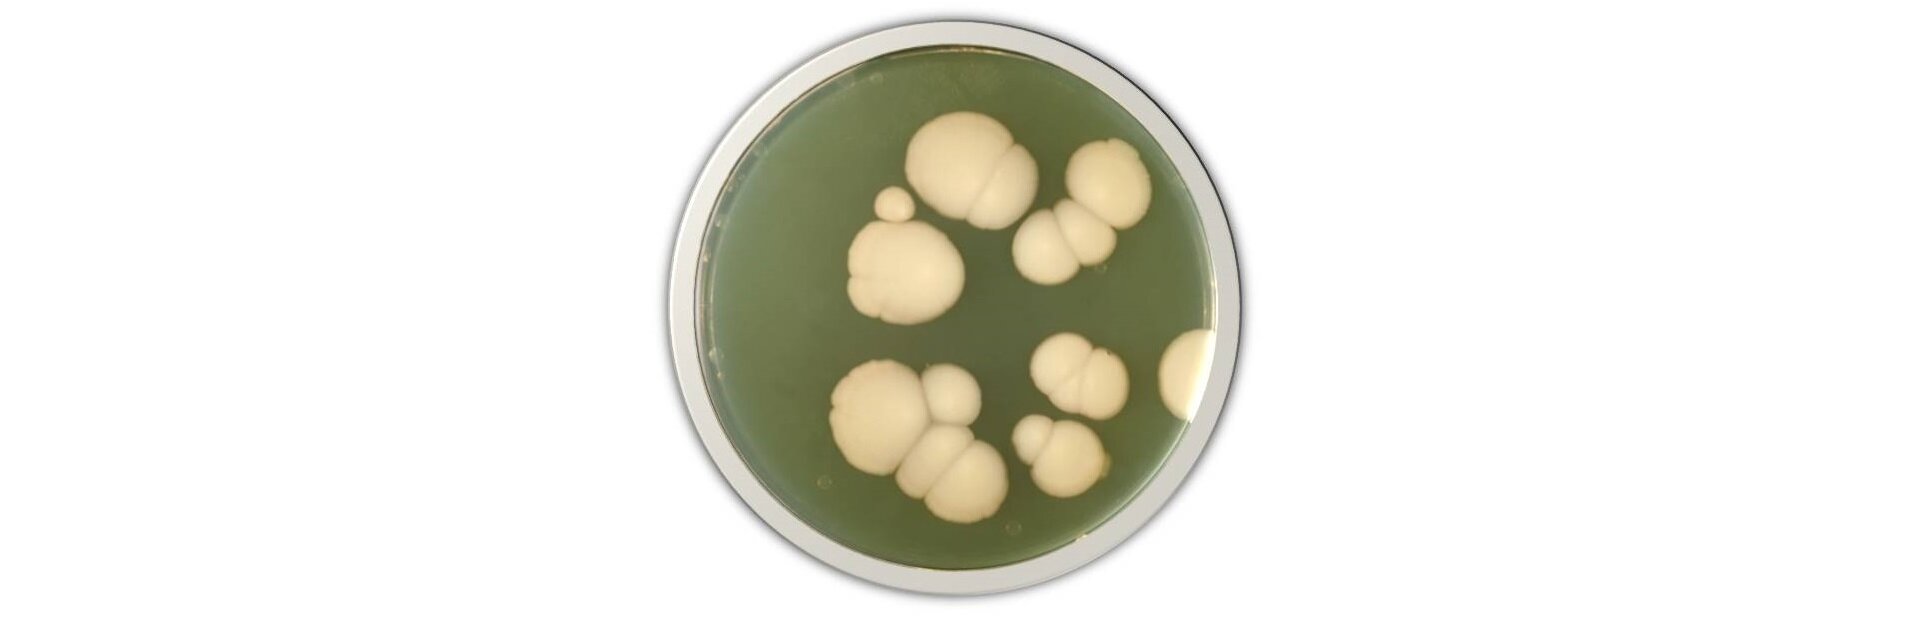
Na zdjęciu na szalce Petriego znajduje się jasnożółta pożywka. Na jej powierzchni są drobnoustroje - skupisko wielu, drobnych komórek.  Są jaśniejsze od pożywki.

Przeczytaj
Zastosowanie monosacharydów
Glukoza i fruktoza
Syrop glukozowy (glukoza cukiernicza) to oczyszczone i zagęszczone wodne roztwory produktów hydrolizy skrobi. Składa się z glukozy (94‑98%), maltozy (1‑3%), maltodekstryny (0,3‑0,5%), polisacharydów (do 2%) i wody. Syrop glukozowy znajduje zastosowanie w przemyśle cukiernicznym, chłodniczym, piekarniczym, owocowo‑warzywnym, spirytusowym oraz farmaceutycznym.

Syrop glukozowo‑fruktozowy (HFCSHFCS) – to oczyszczone i zagęszczone wodne roztwory cukrów prostych w różnych proporcjach, uzyskiwane w wyniku hydrolizy enzymatycznej lub kwasowej skrobi. Wyróżnia się kilka rodzajów syropów:
HFCS‑42 – zawiera do 42% fruktozy; wykorzystywany do produkcji napojów, żywności przetworzonej, płatków zbożowych i wypieków, najpopularniejsza substancja słodząca w Europie.
HFCS‑55 – zawiera od 42 do 55% fruktozy; wykorzystywany do produkcji napojów bezalkoholowych, najpopularniejsza substancja słodząca w USA i Kanadzie.
HFCS‑65 – wykorzystywany w automatach Coca‑Cola Freestyle.
HFCS‑90 – zawiera do 90% fruktozy.

HFCS charakteryzuje niska cena w porównaniu do innych substancji słodzących, co sprawia, że jest chętniej stosowany przez przemysł spożywczy niż sacharoza. Spożywanie dużej ilości produktów, które zawierają syrop glukozowo‑fruktozowy, może powodować szybkie przybieranie na wadze ze względu na zaburzenia odczuwania głodu i sytości, ponieważ fruktoza nie stymuluje wydzielania hormonów regulujących pracę ośrodka głodu i sytości: insuliny i leptyny. Dodatkowo zwiększa ryzyko wystąpienia cukrzycy typu 2, przyczynia się do zwiększenia możliwości wystąpienia zespołu jelita drażliwego, a nawet sprzyja rozwojowi nowotworu jelita grubego u myszy.
Ryboza
Suplement diety dla sportowców – ryboza rozpoczyna procesy metaboliczne, mające na celu syntezę ATP. Sportowcy przyjmują ją podczas wyczerpujących treningów jako wsparcie dla rozwoju mięśni i skrócenie czasu regeneracji zasobów energii.

Ksyloza
Stosowana jako polepszacz smaku i zapachu żywności. Jest suplementem diety i składnikiem testów diagnostycznych. Ma właściwości grzybobójcze oraz antybakteryjne – używa się ją podczas zwalczania chorób jamy ustnej.
Mannoza
Suplement w leczeniu dróg moczowych – stosowany przy zakażeniach i infekcjach pęcherza. Mannozę wykorzystuje się zarówno w przypadku ostrych stanów zapalnych, jak i tych drobnych. Przyjmowana regularnie pozwala na utrzymanie pęcherza w czystości i niedopuszczenie do namnażania się bakterii.
Zastosowanie disacharydów
Sacharoza
Głównym składnikiem cukru trzcinowego, pochodzącego z łodyg trzciny cukrowej, jest właśnie sacharoza. Cukier trzcinowy należy do cukrów nierafinowanych, a więc nieoczyszczonych, dzięki czemu posiada w swoim składzie składniki mineralne (żelazo, potas, magnez i wapń).

Cukier buraczany (cukier biały, cukier spożywczy) – pochodzi z buraków cukrowych, nazywany jest białą śmiercią, a jego głównym składnikiem jest sacharoza. Cukier buraczany, w odróżnieniu do cukru trzcinowego, pozbawiony jest jakichkolwiek wartości odżywczych, ze względu na proces rafinowaniarafinowania, który zachodzi podczas jego produkcji. Rodzajem cukru buraczanego jest cukier brązowy, z którego początkowo wyodrębnia się melasęmelasę, a później ponownie się ją dodaje. Cukier brązowy, pomimo podobnego wyglądu do cukru trzcinowego, nie zawiera witamin i składników mineralnych.
Laktoza
Laktoza jest składnikiem mieszanin dymotwórczych. Świece dymne stosuje się najczęściej w wojsku, ratownictwie oraz w fotografii. Stosuje się laktozę również jako substancję pomocniczą w tabletkach, ponieważ jest stabilna i nietoksyczna, nie wchodzi w interakcje z innymi składnikami leku oraz pozytywnie wpływa na poprawę smaku. Jest stosowana także jako substancja neutralna, dodawana podczas przygotowywania rozcieńczonych proszków (rozcierekrozcierek), które zawierają substancje silnie działające lub higroskopijne w recepturze aptecznej.
Maltoza
Maltoza jest środkiem słodzącym, ale wchodzi również w skład mieszaniny związków chemicznych, umożliwiających hodowlę bakterii lub grzybów pożywek.
Zastosowanie polisacharydów
Celuloza
Celuloza wykorzystywana jest do produkcji papieru – spilśniona na sicie masa włóknista wykonana z celulozy. W postaci celulozy mikrokrystalicznej (symbol E460) używana jest jako dodatek w suplementach diety. Odpowiada za zapobieganie zbrylaniu się sypkich preparatów lub zagęszczanie i żelowanie płynnych substancji. Kompresy wykonane z celulozy stosowane są do dezynfekcji skóry przed iniekcją podczas zabiegów ambulatoryjnych, a także do opatrywania skaleczeń i ran. Także nici chirurgiczne są wykonane z celulozy.
Triazotan(V) celulozy
Ester celulozy i kwasu azotowego(V), w którym trzy grupy azotanowe(V) przypadają na jedną jednostkę glukozową.

Bawełna strzelnicza – materiał stosowany do produkcji prochu bezdymnego. Na powietrzu spala się jasnym, żółtym płomieniem, nie pozostawiając zapachu ani widocznych pozostałości. Emituje bardzo duże ilości ciepła – spalenie jednego grama jest odczuwalne dwa metry od źródła (spalenie).
Octan celulozy
Ester kwasu octowego i celulozy.

Błony fotograficzne – obecnie octan celulozy stanowi bezpieczne podłoże o wysokiej przejrzystości dla błony fotograficznej. Podczas przetłaczania roztworu octanu celulozy w acetonie przez otwory dyszy przędzalniczej następuje odparowanie rozpuszczalnika, dzięki czemu tworzy się stałe włókno. Na podłoże nanosi się warstwę emulsji światłoczułej.

Włókna wiskozowe
Rodzaj włókna powstającego w wyniku chemicznej obróbki celulozy. Włókna wiskozowe produkowane jako włókna ciągłe (np. sztuczny jedwab, kord) lub cięte (bawełnopodobne i wełnopodobne).
Sztuczny jedwab to cienkie włókna wiskozowe, które tworzą nitki materiału, stosowane do produkcji ubrań. W przeciwieństwie do jedwabiu charakteryzują się większą odpornością na promieniowanie UV, ale gorszą wytrzymałością.
Włókna bawełnopodobne wykorzystywane są w artykułach higienicznych oraz artykułach gospodarstwa domowego.
Skrobia
Skrobię możemy znaleźć w mączce sago, którą przeznacza się w żywieniu dzieci.

Słownik
proces oczyszczania i uszlachetniania substancji naturalnych lub produktów przemysłowych w celu nadania im odpowiednich właściwości
gęsty ciemnobrunatny syrop, będący produktem ubocznym przy wyrobie cukru
rozcieńczenie proszków, zawierających silnie działające bądź higroskopijne substancje, przy pomocy składników neutralnych
rodzaj mączki wyrabianej z wnętrza palmy sagowej i niektórych sagowców
wysoko‑fruktozowy syrop kukurydziany (ang. high‑fructose corn syrup)
Bibliografia
Litwin M., Styka‑Wlazło Sz., Szymońska J., To jest chemia 2, Warszawa 2016.
McMurry J., Chemia organiczna, tłum. Henryk Koroniak i in., t. 4, Warszawa 2018.